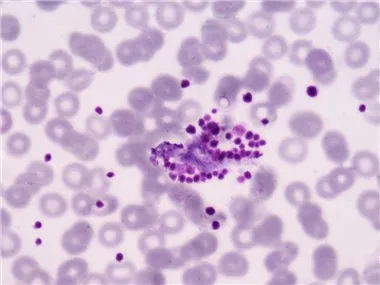
التخثر / الارقاء نموذج مرض الرئيسيات غير البشرية

نموذج مرض فرط الحساسية المتأخر (DTH) غير البشري
فرط الحساسية من النوع المتأخر (DTH)، ويسمى أيضًا فرط الحساسية من النوع الرابع، هو استجابة مناعية شائعة تحدث من خلال العمل المباشر للخلايا التائية الحساسة عندما يتم تحفيزها عن طريق الاتصال بالمستضد. يشار إليها على أنها استجابة متأخرة حيث أنها تتطلب عادةً ما بين 12 إلى 24 ساعة على الأقل حتى تظهر علامات الالتهاب محليًا.
فرط الحساسية من النوع المتأخر (DTH)
أعراض المرض:طفح جلدي، رد فعل أكزيمائي
الأسباب:على عكس فرط الحساسية من النوع الأول والثاني والثالث، والذي يتضمن بشكل أساسي استجابة الجسم المضاد (الخلطية)، فإن DTH هو نوع من الاستجابة الخلوية. تتضمن هذه الاستجابة تفاعل الخلايا التائية والخلايا الوحيدة والبلاعم.
يحدث هذا التفاعل عندما تتعرف خلايا CD4+ Th1 على مولد مضاد غريب في مجمع به فئة MHC II على سطح الخلايا المقدمة للمستضد، مما يحفز تكاثر خلايا CD4+ Th1. تفرز الخلايا التائية CD4+ IL-2 وإنترفيرون جاما (IFN-)، مما يؤدي إلى إطلاق مزيد من السيتوكينات Th1 الأخرى، وبالتالي يتوسط الاستجابة المناعية. تقوم الخلايا التائية CD8+ المنشطة بتدمير الخلايا المستهدفة عند التلامس، في حين تنتج البلاعم المنشطة إنزيمات هيدرولية، وعند ظهورها مع بعض مسببات الأمراض داخل الخلايا، تتحول إلى خلايا عملاقة متعددة النوى.
يؤدي رد الفعل المفرط للخلايا التائية المساعدة والإفراط في إنتاج السيتوكينات إلى إتلاف الأنسجة والتسبب في الالتهاب وموت الخلايا.
مزايا نموذج NHP DTH
تصميم الدراسة ونقاط النهاية السريرية
تصميم الدراسة:

نقاط النهاية السريرية:
مراقبة الجلد (طفح جلدي، حمامي)
قياس تصلب الجلد
التشريح المرضي للجلد: سعادة،
IHC: CD3+ خلية T
القرص المضغوط 68+ البلاعم
النتيجة الرئيسية وأسطورة الشكل
اتصل بنا للحصول على مزيد من المعلومات
الوسم : فرط الحساسية من النوع المتأخر (dth) نموذج مرض الرئيسيات غير البشرية، بحث، دراسة، قرد، العلاج الجيني
في المادة التالية
نموذج الصدفيةقد يعجبك ايضا
إرسال التحقيق